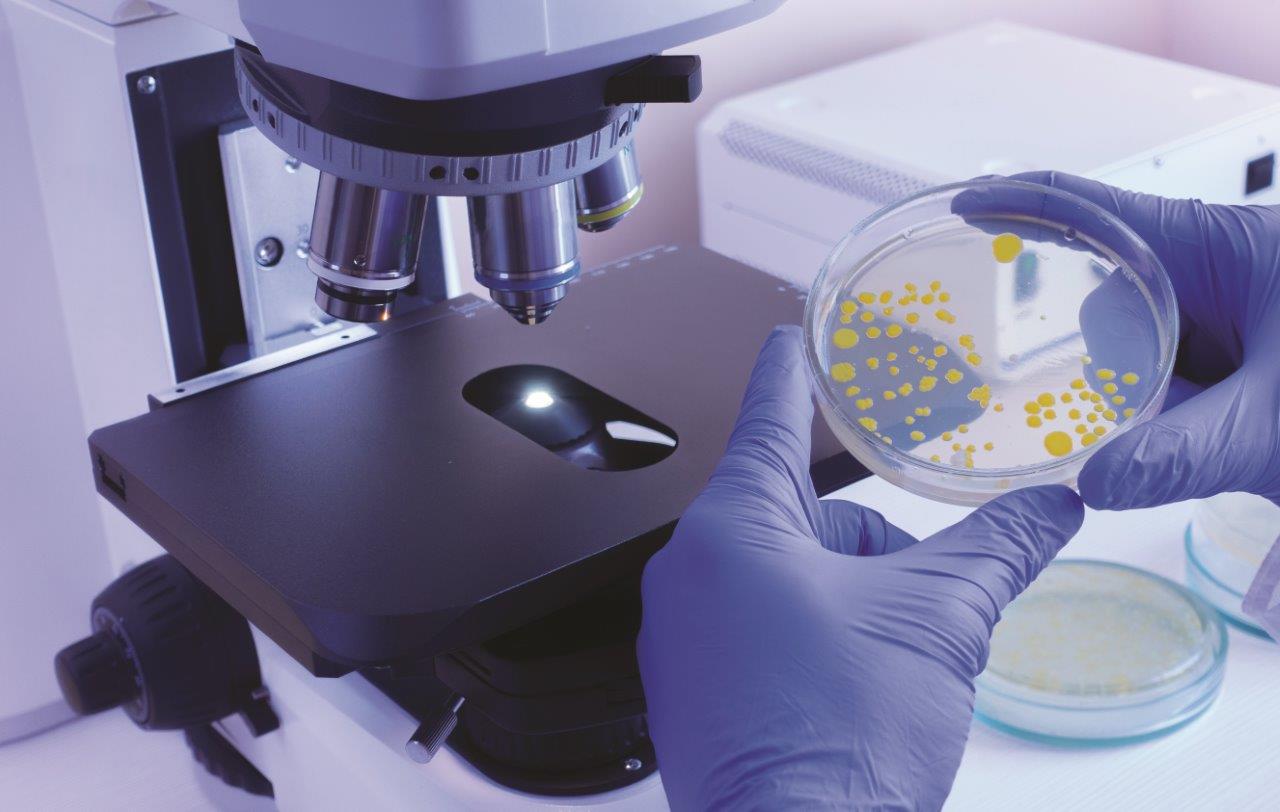

Ausili visivi e strumenti ingrandenti a Trieste
L’Ottica Avanzo è da anni specializzata nella vendita di ausili visivi e strumenti ingrandenti di vario tipo. Garantiamo spedizioni nelle provincie di Gorizia, Pordenone e Udine e nelle zone di confine in Slovenia.
Strumenti ingrandenti
Offriamo un vasto assortimento di strumenti ottici da utilizzare per i più svariati usi, da quello professionale, lavorativo a quello hobbystico. I prodotti sono di aziende certificate che ne garantiscono l’affidabilità e la sicurezza. Eschebach, Ziel, CentroStyle, Yukon, Celestron vantano una pluriennale esperienza nel settore. Siamo specializzati in diversi tipi di ausili visivi, nonchè strumenti ingrandienti dei più diversi tipi.
Binocoli Cannocchiali
Perfetti per il tempo libero e le attività all'aria aperta. Adatti per ogni esigenza al mare o in montagna, per viaggi, birdwatching, teatro e molto altro. Pratici e precisi, di qualità garantita.
Trattiamo un vasto assortimento di prodotti ZIEL CAI ESCHENBACH.
La maggior parte dei prodotti con GARANZIA A 10 ANNI